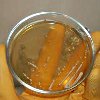

Запись
740₽
+7+7 ( ..показать +7+7 (812) 507-54-54
Кдц Им. Г.и. Турнера На Лахтинской Улице Санкт-Петербург; ул. Лахтинская, д. 12, лит. А ; м. Чкаловская
Запись
830₽
+7(996 ..показать +7(499) 11-68-239+7(996) 051-26-36 +7(861) 212-52-88
ЭкспрессМедСервис на Ставропольской Краснодар; ул. Ставропольская, д. 96/1 ;
Запись
900₽
+7(812 ..показать +7(499) 11-68-239+7(812) 943-84-86 +7(812) 934-56-64
АМДЦ на Орбели Санкт-Петербург; ул. Орбели, д. 19 ; м. Площадь Мужества
Запись
1050₽
+7(499 ..показать +7(499) 11-68-239+7(499) 252-59-99
УРО-ПРО на Конюшковской Москва; ул. Конюшковская, д. 26 ; м. Краснопресненская
Запись
1100₽
+7(499 ..показать +7(499) 11-68-239+7(499) 653-71-21
МедСемья на Брусилова Москва; ул. Брусилова, д. 21 ; м. Юго-Западная
Запись
1200₽
+7(495 ..показать +7(499) 11-68-239+7(495) 363-03-63 +7(800) 200-36-30
ИНВИТРО на Хорошевском шоссе Москва; Хорошевское шоссе, д. 22 ; м. Беговая
Запись
1200₽
+7(495 ..показать +7(499) 11-68-239+7(495) 363-03-63 +7(800) 200-36-30
ИНВИТРО в 1-м Кожуховском проезде Москва; 1-й Кожуховский проезд, д. 9 ; м. Автозаводская
Запись
1275₽
+7(499 ..показать +7(499) 11-68-239+7(499) 641-13-02
МедЦентрСервис в Медведково Москва; ул. Полярная, д. 32 ; м. Медведково
Запись
1275₽
+7(499 ..показать +7(499) 11-68-239+7(499) 519-39-85 +7(499) 641-13-02
МедЦентрСервис в Коньково Москва; ул. Миклухо-Маклая, д. 43 ; м. Беляево
Запись
1275₽
+7(499 ..показать +7(499) 11-68-239+7(499) 519-39-77 +7(499) 641-13-02
МедЦентрСервис в Марьино Москва; ул. Новомарьинская, д. 32 ; м. Братиславская
Запись
1275₽
+7(499 ..показать +7(499) 11-68-239+7(499) 641-13-02
МедЦентрСервис на Тверской-Ямской Москва; ул. 1-я Тверская-Ямская, д. 29 ; м. Белорусская
Запись
1275₽
+7(499 ..показать +7(499) 11-68-239+7(499) 519-39-27 +7(499) 641-13-02
МедЦентрСервис в Отрадном Москва; ул. Пестеля, д. 11 ; м. Отрадное
Запись
1275₽
+7(499 ..показать +7(499) 11-68-239+7(499) 641-13-02
МедЦентрСервис в Митино Москва; ул. Митинская, д. 28, корп. 3 ; м. Митино
Запись
1320₽
+7(495 ..показать +7(499) 11-68-239+7(495) 023-60-84
МЕДСИ в Бутово Москва; ул. Старокачаловская, д. 3, корп. 3 ; м. Бульвар Дмитрия Донского
Запись
1320₽
+7(495 ..показать +7(499) 11-68-239+7(495) 023-60-84 +7(495) 730-14-34 +7(985) 239-51-02
МЕДСИ на Солянке Москва; ул. Солянка, д. 12, стр. 1 ; м. Китай-Город
Запись
1490₽
+7(495 ..показать +7(499) 11-68-239+7(495) 255-30-11
Евромедпрестиж на Донской Москва; ул. Донская, д. 28 ; м. Шаболовская
Запись
1600₽
+7(499 ..показать +7(499) 11-68-239+7(499) 969-21-90 +7(499) 402-92-28
Клиника Столица на Арбате Москва; Большой Власьевский пер., д. 9 ; м. Смоленская
Запись
1670₽
+7(495 ..показать +7(499) 11-68-239+7(495) 331-85-10 +7(495) 331-16-01 +7(495) 331-85-10
Клинический Госпиталь MD GROUP на Севастопольском проспекте Москва; Севастопольский пр-т, д. 24, корп. 1 ; м. Профсоюзная
Запись
1890₽
+7(495 ..показать +7(499) 11-68-239+7(495) 121-04-03
КДС Клиник на Дмитровском шоссе Москва; Дмитровское шоссе, д. 81 ; м. Селигерская
Запись
2100₽
+7(499 ..показать +7(499) 11-68-239+7(499) 372-17-41
Академия здоровья на Большой Грузинской Москва; ул. Большая Грузинская, д. 20 ; м. Баррикадная
Ещё клиник - 237 . Используйте фильтры